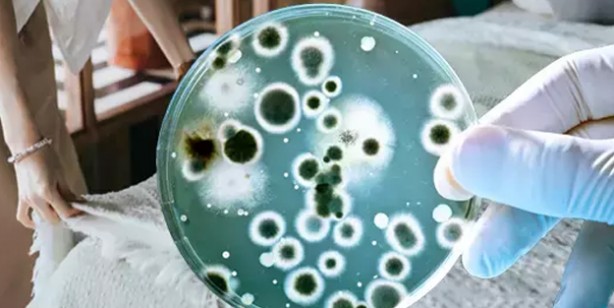
Foto - Uzman isimden korkutan uyarı geldi! Sessizce gelen gizli tehlike: İçinde maalesef mikroplar cirit atıyor! Aman dikkat!

Toz akarlarına karşı özellikle duyarlı olmasanız bile, uyandıktan sonra çarşafların bir süre nefes almasına izin vermek yine de faydalı olabilir. Genel olarak nemi tekstil ürünlerine ve birçok ortama hapsetmek akıllıca bir fikir değil. milliyet'in derlediği haberde: Çünkü bakteri, küf ve koku için üreme alanı haline gelebilir. Semptomsuz uyuyabildiğinizi fark ederseniz, sabah kalkar kalkmaz yatak toplama rutinize devam edebilirsiniz. Ancak yataktayken alerjiye bağlı rahatsızlık hissediyorsanız bu yeni alışkanlığı denemeniz faydalı olabilir ifadeleri aktarıldı.